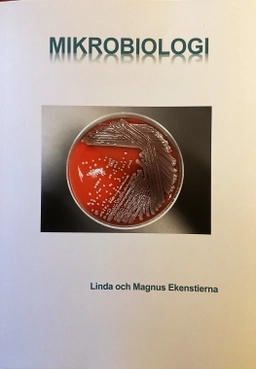
Mikrobiologi; Linda Ekenstierna; 2025

Mikrobiologi Faktabok - för gymnasieskolanUpplaga 3
- Upplaga: 3e upplagan
- Utgiven: 2007
- ISBN: 9789144048222
- Sidor: 168 st
- Förlag: Studentlitteratur AB
- Format: Häftad
- Språk: Svenska
Om boken
Åtkomstkoder och digitalt tilläggsmaterial garanteras inte med begagnade böcker
Mer om Mikrobiologi Faktabok - för gymnasieskolan (2007)
I juli 2007 släpptes boken Mikrobiologi Faktabok - för gymnasieskolan skriven av Magnus Ekenstierna, Linda Ekenstierna. Det är den 3e upplagan av kursboken. Den är skriven på svenska och består av 168 sidor djupgående information om teknik. Förlaget bakom boken är Studentlitteratur AB som har sitt säte i Lund.
Köp boken Mikrobiologi Faktabok - för gymnasieskolan på Studentapan och spara pengar.
Tillhör kategorierna
Referera till Mikrobiologi Faktabok - för gymnasieskolan (Upplaga 3)
Harvard
Oxford
APA
Vancouver